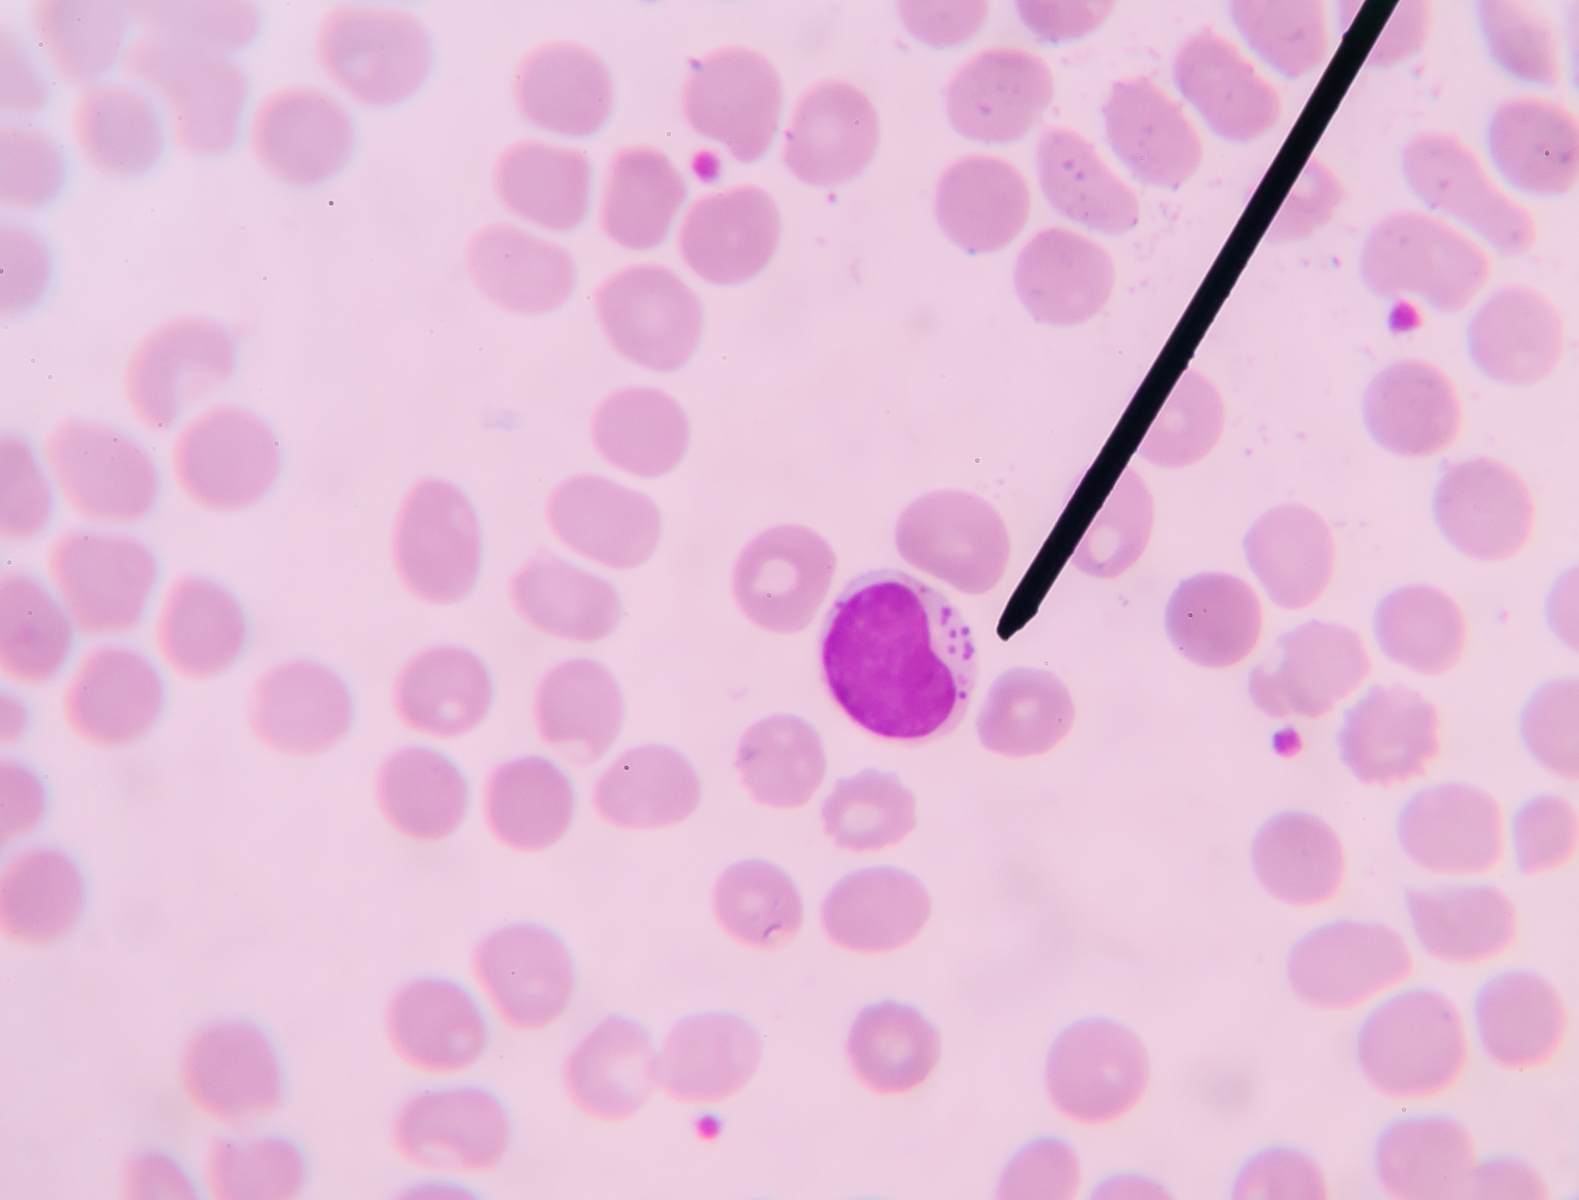

Lymfoomat eivät ole yksi sairaus, vaan yli sadan erilaisen sairauden muodostama sairausryhmä. Ihmisen valkosolut huolehtivat elimistön puolustuksesta ulkoisia vihollisia kuten bakteereja ja viruksia vastaan. Lymfosyytit ovat osa tätä puolustusjärjestelmää. Ne partioivat
imusolmukkeissa
luuytimessä
pernassa
kateenkorvassa
sekä tarvittaessa myös muissa elimissä etsien tuhottavia vihollisia.
Lymfooma syntyy, kun yhden imusolun geenistöön kertyy riittävä määrä kriittisiä virheitä. Ne muuttavat kehon oman solun pahanlaatuiseksi syöpäsoluksi, joka puolestaan lähtee kasvamaan hallitsemattomasti muodostaen syöpäkasvaimia.
Vuonna 2021 Suomessa todettiin miehillä 1268 ja naisilla 941 uutta lymfoomatapausta. Lymfoomia tavataan kaiken ikäisillä, mutta sairastumisriski kasvaa iän myötä. Sairastumisriski on vahvasti ympäristösidonnaista ja myös sairauksien kirjo vaihtelee maapallon eri alueilla. Länsimaisissa yhteiskunnissa on nähty voimakas lymfoomien yleistyminen koko sen ajan, kun käytössä on ollut luotettavia syöpärekisterejä. Ilmaantuvuuden kasvu on ollut pitkään noin 3 prosenttia vuodessa. Tällä hetkellä se on hidastunut, mutta lievää kasvua nähdään edelleen.